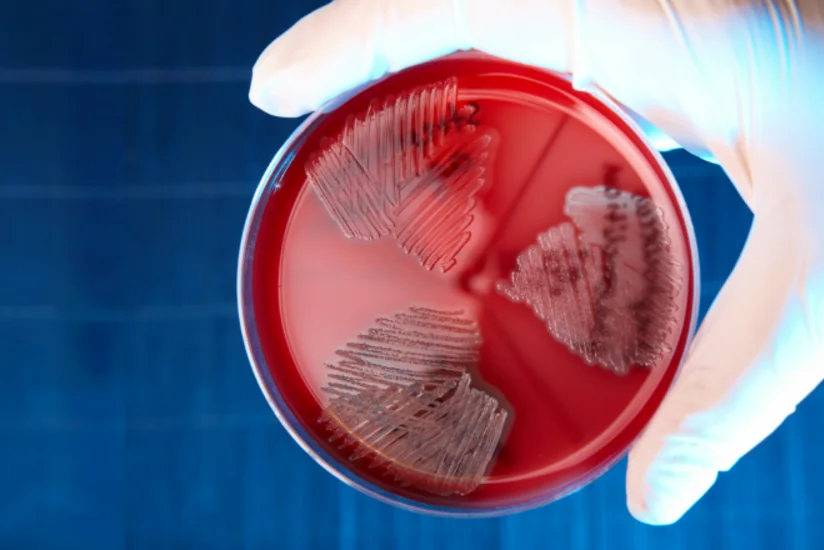
At least 27 people fall ill with streptococcal infection in Hong Kong

At least 27 people fall ill with streptococcal infection in Hong Kong
Other countries
- 16 September, 2024
- 05:40
Hong Kong’s health minister, Lo Chung-mau, has urged residents to be careful when handling freshwater fish after 27 people were infected with the potentially deadly Group B Streptococcus, Report informs referring to the South China Morning Post.
The Centre for Health Protection (CHP) said the cause of the infection was related to handling and contact with raw freshwater fish.
Hong Kong experienced a similar outbreak in 2021, with more than 50 people infected with the same strain, known as ST283 or serotype III sequence type 283.
Latest News
23:11
Video
Vučić calls Ilham Aliyev an experienced statesman and national leader
Foreign policy22:59
Photo
President of Azerbaijan Ilham Aliyev and President of Serbia Aleksandar Vučić delivered press statements - UPDATED
Foreign policy22:26
Vučić: 1st meeting of Azerbaijan-Serbia Strategic Partnership Council is a turning point
Foreign policy22:18
President: 'The broader region is developing very rapidly, with a lot of unexpected scenarios'
Foreign policy22:12
Azerbaijan-Serbia cooperation across various sectors discussed in Belgrade
Foreign policy22:07
Ilham Aliyev: 'We not only work closely on the political track, on the international arena, but we also implement important projects'
Foreign policy22:02
Aleksandar Vučić: 'I'm going to visit Azerbaijan relatively soon again'
Foreign policy21:54
Ilham Aliyev: Azerbaijan and Serbia are very friendly countries
Foreign policy21:45
